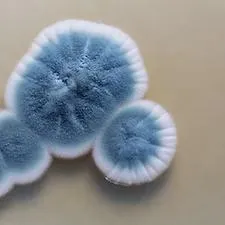

A yearly inspection that evaluates the overall condition of your home, helping you spot issues early, and to plan for maintenance. ($299)
Detects hidden mold spores in your home’s air to identify potential health risks and ensure a safe indoor environment. ($495)

Measures radon gas levels in your home to identify risks and ensure your indoor air is safe and healthy. ($275)

Screens your home’s water for common contaminants to ensure it’s clean, safe, and healthy for everyday use. ($199)

Broader analysis of your water quality, checking for additional contaminants to safeguard long-term health and home safety. ($399)

Modern Home Inspections provides comprehensive water quality testing that protects Connecticut families from contaminated drinking water. We test both well water and municipal supplies for bacteria, chemicals, heavy metals, and other harmful contaminants using advanced laboratory analysis. Our certified technicians provide clear results and practical recommendations, giving you peace of mind about your family's water safety.
Professional radon testing from Modern Home Inspections protects Connecticut families from this invisible, cancer-causing gas found in many homes. We use EPA-approved equipment to accurately measure radon levels in air and water, providing reliable results you can trust. Our certified technicians deliver clear findings and practical recommendations for mitigation if elevated levels are detected.


Indoor air quality testing from Modern Home Inspections identifies hidden mold problems that can affect your family's health. We use advanced air sampling and surface testing techniques to detect mold species and concentration levels throughout your Connecticut home. Our certified inspectors provide detailed analysis and remediation recommendations to protect your family's wellbeing.
Our thorough inspections cover every inch of your property. From foundation to roof, we ensure no detail is overlooked, giving you an accurate snapshot of your investment’s condition.
With our expert analysis, we identify potential risks and provide actionable recommendations, allowing you to address issues before they impact your investment’s value.

Our inspection reports are designed for clarity. With detailed photos, concise descriptions, and actionable advice, you’ll have all the information you need to make informed decisions.
From the initial inspection to long-term maintenance advice, our team is dedicated to supporting you throughout your property’s lifecycle, ensuring it remains in top condition.

"Working with Modern Home Inspections was an absolute game-changer for our home purchase. Their inspection team provided us with a detailed, clear report that highlighted both the obvious and hidden issues with the property. We felt fully informed and confident in our decision-making process. The professionalism and thoroughness of their service made a significant difference. I highly recommend them to anyone looking to make smart, informed home buying decisions."
Modern Home Inspections is committed to delivering exceptional residential property inspections. Our certified team ensures Connecticut families make informed decisions by providing comprehensive and dependable reports. Whether you're buying your first home, selling your current property, or maintaining your investment, trust us to be your partner every step of the way.
© Modern Home Inspections. 2025. All Rights Reserved. Built by EchoDesk